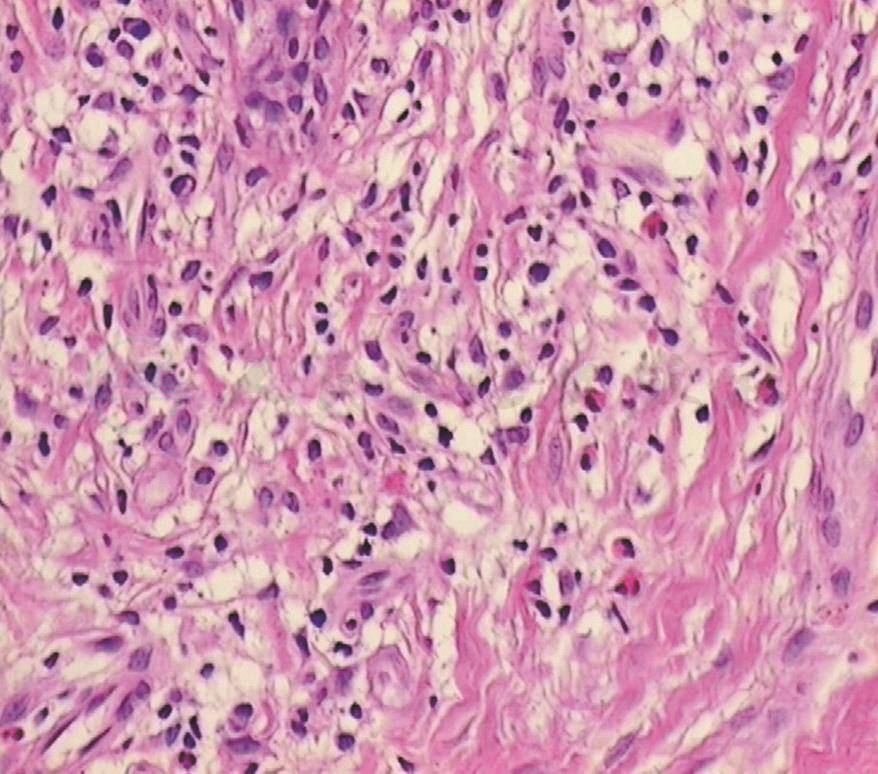

患者,男,78岁,退休。
主诉:全身红斑、丘疹反复30年泛发,红皮8个月。
现病史:患者30年前青霉素过敏后出现红丘疹,经治痊愈,此后四肢躯干反复出现红丘疹,伴有瘙痒,在多家医院诊断为湿疹,服用中药和外用药物治疗,时轻时重。8个月前在某诊所静脉滴注不明药物后,全身泛发红斑,逐渐发展至全身弥漫潮红,瘙痒明显,期间在外院治疗。外周血嗜酸性粒细胞明显升高,在10%~30%之间波动,抗组胺等药物治疗,效果不佳。患者情况可,无发热、关节痛等症状。
既往史、家族史:既往体健,有青霉素过敏史,否认家族中有类似病例。
体格检查
一般情况:尚可,腹股沟区淋巴结肿大,双下肢稍肿,其他系统检查未见明显异常。
专科情况:全身皮肤弥漫潮红,粗糙,部分呈苔藓样改变,可见散在圆顶丘疹,色素沉着,细白脱屑,头皮为甚(图1~2)。

图1 面部、头皮皮肤弥漫潮红,粗糙,部分呈苔藓样改变

图2 背部皮肤弥漫潮红,粗糙,部分呈苔藓样改变,可见散在圆顶丘疹
辅助检查
血常规:WBC基本正常,EO% 15%~40%(正常值0.5%~5%);EOS计数:1.7~4.83×109/L(正常值0.05~0.50×109/L);IgE>5000KU/L;多次检查粪寄生虫虫卵阴性;ESR 46mm/h;IgA、IgG增高,IgM正常;补体CH50/C3:降低;生化全项:TP 53g/L,ALB 21g/L,A/G 0.7,余正常。尿常规、ECG、胸片均正常;HbsAg、TPHA均阴性;腹部B超:胆囊多发结石,多发息肉。M超:二尖瓣、三尖瓣反流,左室舒张功能减低。
组织病理:表皮角化不全,角化不良,真皮小血管周围较多淋巴细胞、嗜酸性粒细胞浸润(图3~4)。腋下淋巴结活检:淋巴组织增生伴组织细胞增生。骨髓象:骨髓增生活跃M/E=5.8,嗜酸性粒细胞比例明显增高,占15%(正常值0~6.22%),嗜酸性粒细胞形态未见明显异常。

图3 表皮角化不全,角化不良
图4 真皮小血管周围较多淋巴细胞、嗜酸性粒细胞浸润
住院期间给予糖皮质激素治疗(泼尼松30mg/d)2周后明显好转,复查WBC:10.5×109/L,嗜酸性粒细胞计数:0.04×109/L。近1年多泼尼松减至10mg/ d维持,并口服中草药治疗,现皮损基本消退。该患者治疗期间曾自行停用泼尼松,病情出现反复,反复时嗜酸性粒细胞计数增多。